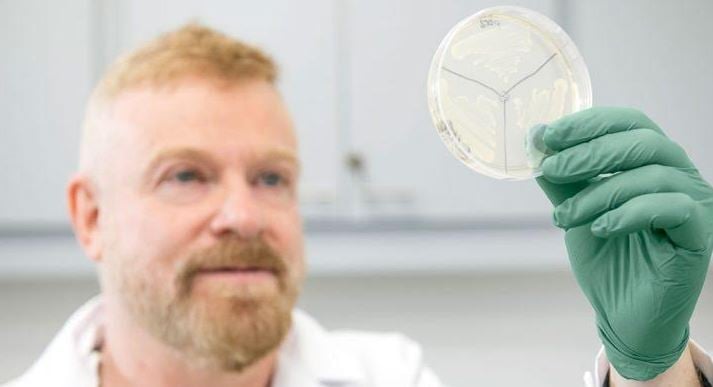

El destacado científico Gabriel Rabinovich elogió al Instituto del Cáncer y al recurso humano de Misiones
El destacado científico Gabriel Rabinovich, diserta este viernes en Posadas luego de recorrer y elogiar el Instituto Misionero. Recibió innumerables galardones por su trayectoria, la relevancia de sus hallazgos y proyectos que buscan generar terapias para diferentes enfermedades inmunológicas.
El destacado científico Gabriel Rabinovich, diserta este viernes en Posadas luego de recorrer y elogiar el Instituto Misionero. Recibió innumerables galardones por su trayectoria, la relevancia de sus hallazgos y proyectos que buscan generar terapias para diferentes enfermedades inmunológicas.







